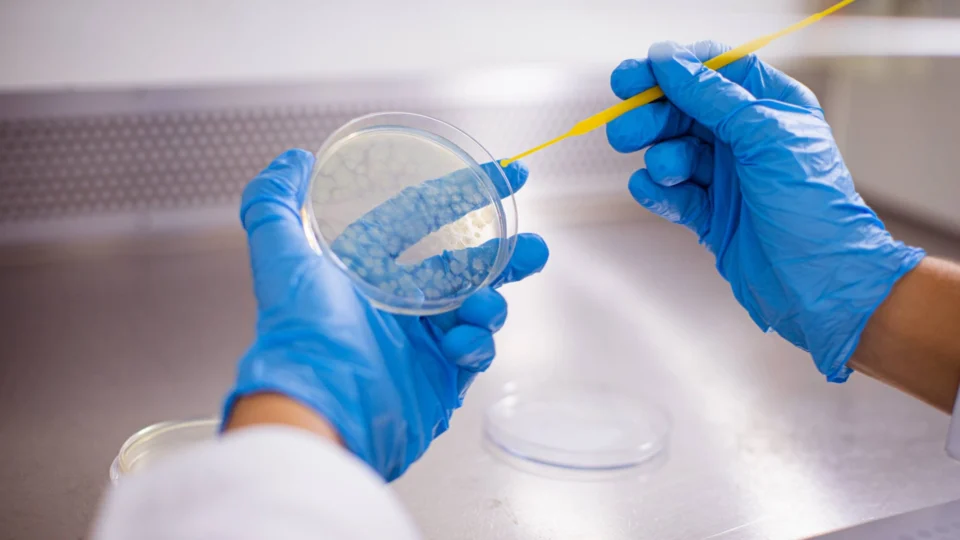
Comissão aprova PLP que impede corte de despesas com bolsas de pesquisa

O PLP 199/2021, que proíbe a limitação de despesas orçamentárias com bolsas de estudo, de pesquisa e de auxílios concedidos em instituições de ensino superior, profissional e tecnológico, foi aprovado nesta terça-feira (27), pela Comissão de Educação do Senado.
A proposta é do Senador Jader Barbalho (MDB-PA), o relator é o senador Plínio Valério (PSDB-AM).
+ Envie esta notícia no seu Whatsapp
+ Envie esta notícia no seu Telegram
Valério recordou que embora esse pagamento não seja de execução obrigatória, ele possui natureza alimentar, já que muitos bolsistas não têm outra fonte de renda ou escolhem se dedicar totalmente aos estudos.
Atraso de pagamento de bolsas
Os atrasos no pagamento dessas bolsas de estudos de programas de apoio à formação de professores e o corte de orçamento para pesquisas no Ministério da Ciência e Tecnologia em 2021, foi a principal motivação do projeto.
“Temos que evitar a todo custo situações como a verificada no fim de 2022, quando 200 mil bolsistas foram surpreendidos com a informação de que a Capes, órgão responsável pelo pagamento das bolsas de ensino superior, não teria autorização orçamentária suficiente para honrar os pagamentos das bolsas de estudos e de pesquisa, por causa de bloqueios orçamentários determinados pelo Ministério da Economia”, disse o senador.
Ainda segundo o relator, não há restrições na legislação de finanças públicas para a aprovação da proposta.
RELACIONADAS
+ Novos valores de bolsas de pesquisa são anunciados pelo governo federal
+ Capes lança ‘Ciência é 10!’ com mais de 3 mil vagas para qualificação de professores
+ VÍDEO: Lula anuncia novos valores das bolsas CAPES, CNPq e Bolsa Permanência
Conforme o congressista, o texto alterado existe para evitar que despesas críticas sejam sujeitas à incerteza de limitações cíclicas do orçamento causadas por políticas econômicas.
“Comprometer a entrada de novos estudantes no sistema que forma os futuros cientistas e pesquisadores é condenar a economia à estagnação tecnológica, a pior possível nesta era em que o conhecimento é fator de produção primordial”, defendeu Valério.
Agora o PLP 199/2021 segue para ser analisado pela Comissão de Assuntos Econômicos (CAE).